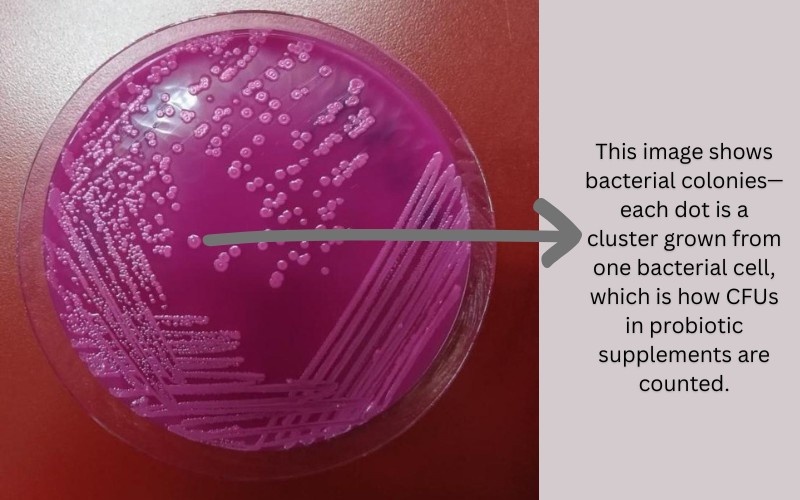
Bacterial colony

Bloating, gas, and that uneasy “something’s not right” feeling in the stomach have become everyday issues for many of us. We blame it on “bad digestion” or “stress,” but there’s a whole lot more happening inside. From mood to immunity to energy levels—all these issues can point back to your gut, throwing a mini tantrum. When the bacterial ecosystem in our gut gets out of balance, all kinds of symptoms start appearing. And that’s exactly where pre and probiotic capsule uses come in.
In this guide, we’re going to dive deep into prebiotics and probiotics, what they are, how they work, and how they can genuinely impact your everyday health.
Let’s decode it, microbiology-style, but made easy!
What Are Prebiotics and Probiotics?
There’s a tiny but bustling world of trillions of microbes (bacteria) living in your gut (your small & large intestine). Think of it as a “microbiome city” where good, bad, and neutral bacteria live together in a delicate balance.
These microorganisms live in symbiosis (mutualism) with each other and your body. They help in digestion, immunity, vitamin production, nutrient absorption, and even mood regulation (thanks to the gut-mind connection). In return, they live off the nutrients & fibers we provide through our diet.
This unity works only when the balance is maintained. If bad bacteria start to outnumber the beneficial ones, the whole system gets disturbed, leading to bloating, indigestion, and other problems.
But why does this balance break? Because your good bacteria need the right “food” to survive—fruits like bananas and whole grains. But when your diet lacks these and is filled with junk & oily foods, along with a lot of sugar, the good bacteria shrink in number, and the bad ones start multiplying quickly.
And this is exactly where prebiotics and probiotics come into the picture.

Probiotics are the good bacteria themselves—the helpful microbes that your gut needs.
Prebiotics are the food for those good bacteria—the high fiber foods that help them grow, stay strong, and keep the harmful bacteria under control.
Think of prebiotics as the fertilizer and probiotics as the seed. Together, they make a flourishing garden.
Probiotics and prebiotics together restore & maintain the balance of your “microbiome city,” supporting smoother digestion and overall better gut health.
Pre and Probiotic Capsules Uses

Pre and probiotic capsules restore your gut microbiome balance, which gives you benefits like:
- Reduced bloating and gas
- Better digestion
- Improved bowel habits
- Stronger immunity
- Clearer skin
- More stable mood and energy
- Better nutrient absorption
A balanced gut is like resetting your internal system; it only has benefits and influences almost everything.
It’s like having a second digestive system. Microbes break down the parts of food our bodies cannot, producing useful by-products like SCFAs, which can be used to generate energy and nutrients.
However, achieving this level of microbiome balance is not magical; it’s complementary. The microbiome improves efficiency, but it cannot make up for a poor diet and lack of nutrients. Completing your vitamin and mineral deficiency is still crucial.
And remember, your results depend on which bacteria you host and how well-balanced your gut community is. Different microbial combinations lead to different outcomes.
Do Probiotics Help You Lose Weight?
Not a dramatic yes, but yes! Some studies have done research on this topic and have found positive results. One of the systematic reviews suggested that probiotic supplements do help with weight management in overweight or obese people. They reported significant reductions in body weight and body mass index (BMI) along with reductions in waist circumference and total body fat mass.
They also stated that a multistrain probiotic, especially with genera like Lactobacillus and Bifidobacterium, worked most effectively.
However, probiotics alone don’t guarantee significant weight loss. Another research published in Nature studied 58 Egyptian women who were overweight or obese.
They combined a low-calorie, high-fiber diet (prebiotic preparation) with probiotic supplementation (daily yoghurt) and regular exercise for over 3 months.
In the results, they saw significant improvements in body weight, BMI, waist and hip circumference, fat mass, and overall fat composition in obese women.
So, to answer the question, whether probiotics help you lose weight, yes, they do—but only with a healthy diet, fiber intake, good probiotic intake, daily exercise, and other lifestyle changes.
Natural Sources of Probiotics and Prebiotics
Adding probiotics and prebiotics through your diet is one of the easiest ways to support your gut health. Choosing a natural option should be your priority during non-emergency situations.
What Food is Highest in Probiotics?

These foods already contain beneficial microbes that directly add to your gut community:
- Curd and Yogurt: The most common sources, packed with Lactobacillus strains.
- Buttermilk (Chaach): A light, probiotic-rich drink that’s great for digestion.
- Kefir: A fermented milk drink containing diverse bacteria & yeast cultures.
- Fermented Vegetables: Such as kimchi, sauerkraut, and pickles (only naturally fermented, not vinegar-based).
- Kombucha: A fermented tea with live cultures.
- Idli, Dosa Batter & Other Fermented Indian Foods: Mild but beneficial forms of natural probiotics.
What Food is Highest in Prebiotics? (Food for Good Bacteria)

The high fiber-rich foods are the prebiotics you need for your gut microbes. Below are the natural prebiotics good for your gut:
- Bananas (especially slightly unripe): Rich in resistant starch.
- Garlic and Onions: Contain inulin, a powerful prebiotic fiber.
- Oats and Whole Grains: Offer beta-glucans and resistant starch.
- Legumes: Like chickpeas, beans, and lentils.
- Apples: Contain pectin, a great prebiotic fiber.
- Asparagus, Leeks, and Artichokes: Naturally high in inulin.
How Pre and Probiotics Capsules Work Inside Your Body?

As we are unfolding every truth behind pre and probiotic capsules, let’s discuss what happens once you take the capsule as well.
1. The Journey Begins: You Swallow the Capsule
Once you take the capsule, it travels down your esophagus and reaches your stomach. Where the real challenge begins, as the pH of our stomach is 1.5 to 3.5. Meaning it is highly acidic and kills every type of bacteria.
But we want the good ones (in our capsule) to survive.
2. How Probiotics Survive Stomach Acid
The high-quality pre and probiotic capsule uses a kind of coating that protects the bacteria. The enteric coating, delayed-release technology, or microencapsulation works like:
- A raincoat for the bacteria
- A shield that opens only when the environment becomes safe
- A protective bubble that keeps them alive until they reach the intestines
This coating makes sure the bacteria don’t die in the stomach and stay active for their actual job. Poor quality capsules lack this coating technology, and most of the bacteria die in the stomach.
3. Reaching the Intestines (Where the Magic Happens)
Once the capsule reaches its destination, the small intestine, the coating dissolves. As here the environment is:
- Less acidic
- Rich in Nutrients
- Full of your existing gut microbes
This is the perfect spot for probiotics to settle in.
They attach to the intestinal lining, start multiplying, and begin supporting digestion, immunity, and nutrient absorption.
4. What Prebiotics Do?
As we saw above, prebiotics are not bacteria; they’re special fibers that our body cannot digest, but our good bacteria can.
Once the prebiotics reach the large intestine, they’re fermented by good bugs. And this fermentation process produces:
- Short-chain fatty acids (SCFAs) like butyrate → great for gut lining. Butyrate is also present in Ghee. That is why a moderate amount of ghee intake every day is very beneficial for gut health.
- Anti-inflammatory compounds
- Energy for colon (intestine) cells
- A healthier gut environment
Who Should Take Pre- and Probiotic Capsules?
There are certain times when you should start taking pre and probiotic capsules by consulting with your doctor:
- When you’re on an antibiotic course
- If you’ve a chronic bloating problem
- If you’ve weak digestion
- Your immunity is low
- You have skin concerns
- You have stress-related gut issues
- You travel a lot
What Do Pre and Probiotic Capsules Actually Contain?

If you’ve ever picked up a pre or probiotic capsule, you’ve probably seen words like CFU, Lactobacillus, or FOS on the label. So, what does any of it mean? Let’s break it down below.
Probiotic capsules contain live bacteria. Each bacterium is a single cell, and this count is expressed as CFU (Colony Forming Units). In short, each colony counts as one cell. And CFU simply tells you how many live, active bacteria are present and capable of forming a colony.
In microbiology labs, bacteria grow in the form of colonies on the agar plate. Each colony originates from a single bacterial cell, and in reality, a colony has thousands of bacteria in it. Just as it is shown in the picture. That’s why the industry uses the concept: the number of cells that can grow into colonies = CFU count.
So when a label says 10 billion CFU, it means there are around 10 billion live bacteria present inside the capsule that can actively multiply and support your gut.
A good probiotic usually ranges from 1 billion to 50 billion CFU, depending on the purpose
- Lower CFU (1–5 billion) → everyday gut support
- Mid CFU (10–20 billion) → digestion, bloating, immunity
- Higher CFU (30–50+ billion) → post-antibiotic recovery, chronic gut issues
You don’t need the highest one — you need the right one for your needs.
Different Types of Bacterial Strains in Probiotic Capsules

There are many probiotic and prebiotic products available in the market. They each have different types of bacteria in different amounts. So, understand that this different mix of bacteria can help you with different things.
But there are many common strains/types of bacteria, like:
- Lactobacillus rhamnosus – supports digestion & reduces diarrhea
- Lactobacillus acidophilus – improves gut balance & helps with lactose intolerance
- Bifidobacterium longum – reduces bloating & supports immunity
- Bifidobacterium bifidum – helps your gut barrier stay strong
Multistrain probiotics enhance the overall benefits by doing cell-cell communication, interaction with our body cells, and modulating our immune system. Cell-to-cell communication means these different strains of bacteria communicate with each other for proper mutualism.
A quality capsule clearly lists its strains and not just writes “probiotic blend.” Therefore, make sure whatever you’re buying is of quality and get it prescribed by the doctor.
Prebiotic Fibers Inside Pre and Probiotic Capsules
The capsules that write pre and probiotic both on the label have food for the probiotics as well. You might see ingredients like:
- FOS (Fructooligosaccharides)
- GOS (Galactooligosaccharides)
- Inulin (from chicory root)
- Acacia gum/guar gum
The main purpose of adding so many billions of bacterial cells in the capsules is that not all of them stay in your gut. 50 – 60% of cells die due to stomach acid, then some get flushed away along with the poop, and very few get attached to the wall of your gut. And this attachment and survival is enhanced by prebiotics.
These prebiotics help the new good bugs to survive, grow, and overpower the harmful ones.
Final Takeaway on Pre and Probiotic Capsule Uses
Probiotics are immensely beneficial for your health. Naturally incorporate these healthy bacteria & prebiotics through your diet to take advantage of these tiny creatures. Eating some probiotic foods every day will greatly benefit your gut. And if you have serious digestive issues, contact your doctor to start taking pre- and probiotic capsules.
This guide deeply explains the Pre and probiotic capsule uses and talks about every doubt you might have on probiotics and prebiotics.
For such an easy explanation on daily health and wellness topics, subscribe to my newsletter to get the updates directly in your inbox.
FAQ on Pre and Probiotic Capsule Uses
Prebiotics are food for your good gut bacteria, while probiotics are the live good bacteria themselves.
Signs you may need probiotics include frequent bloating, constipation, weak digestion, or recurring gut discomfort.
People with severely weakened immune systems or serious illnesses should avoid taking probiotics unless advised by a doctor.


2 comments